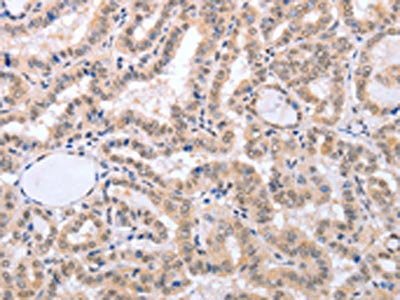

FADD Antibody
-
中文名稱:FADD兔多克隆抗體
-
貨號:CSB-PA221364
-
規格:¥1100
-
圖片:
-
The image on the left is immunohistochemistry of paraffin-embedded Human thyroid cancer tissue using CSB-PA221364(FADD Antibody) at dilution 1/50, on the right is treated with fusion protein. (Original magnification: ×200)
-
The image on the left is immunohistochemistry of paraffin-embedded Human esophagus cancer tissue using CSB-PA221364(FADD Antibody) at dilution 1/50, on the right is treated with fusion protein. (Original magnification: ×200)
-
-
其他:
產品詳情
-
Uniprot No.:
-
基因名:
-
別名:FADD antibody; FADD protein antibody; FADD_HUMAN antibody; Fas (TNFRSF6) associated via death domain antibody; Fas associated via death domain antibody; Fas associating death domain containing protein antibody; Fas associating protein antibody; Fas associating protein with death domain antibody; Fas TNFRSF6 associated via death domain antibody; FAS-associated death domain protein antibody; FAS-associating death domain-containing protein antibody; GIG 3 antibody; GIG3 antibody; Growth inhibiting gene 3 protein antibody; Growth-inhibiting gene 3 protein antibody; H sapiens mRNA for mediator of receptor induced toxicity antibody; Mediator of receptor induced toxicity antibody; MGC8528 antibody; MORT 1 antibody; MORT1 antibody; Protein FADD antibody
-
宿主:Rabbit
-
反應種屬:Human
-
免疫原:Fusion protein of Human FADD
-
免疫原種屬:Homo sapiens (Human)
-
標記方式:Non-conjugated
-
抗體亞型:IgG
-
純化方式:Antigen affinity purification
-
濃度:It differs from different batches. Please contact us to confirm it.
-
保存緩沖液:-20°C, pH7.4 PBS, 0.05% NaN3, 40% Glycerol
-
產品提供形式:Liquid
-
應用范圍:ELISA,IHC
-
推薦稀釋比:
Application Recommended Dilution ELISA 1:1000-1:5000 IHC 1:50-1:150 -
Protocols:
-
儲存條件:Upon receipt, store at -20°C or -80°C. Avoid repeated freeze.
-
貨期:Basically, we can dispatch the products out in 1-3 working days after receiving your orders. Delivery time maybe differs from different purchasing way or location, please kindly consult your local distributors for specific delivery time.
-
用途:For Research Use Only. Not for use in diagnostic or therapeutic procedures.
相關產品
靶點詳情
-
功能:Apoptotic adaptor molecule that recruits caspase-8 or caspase-10 to the activated Fas (CD95) or TNFR-1 receptors. The resulting aggregate called the death-inducing signaling complex (DISC) performs caspase-8 proteolytic activation. Active caspase-8 initiates the subsequent cascade of caspases mediating apoptosis. Involved in interferon-mediated antiviral immune response, playing a role in the positive regulation of interferon signaling.
-
基因功能參考文獻:
- Overexpression of FADD and Caspase-8 suppresses proliferation whilst promoting the apoptosis of human GBM cells. PMID: 28618251
- FADD expression and its phosphorylation can be reliable biomarkers with prognostic value for T-cell lymphoblastic lymphoma stratification. PMID: 27556297
- FADD interference down-regulated Rheb expression and repressed mTORC1 activity in breast cancer cell lines. The autophagy was induced by FADD deficiency in MCF7 or MDA-231 cells but rescued by recovering Rheb expression. PMID: 27013580
- The present data suggests FADD as a putative biomarker for pathological processes associated with the course of clinical dementia. PMID: 28320441
- at normal levels of expression during bacterial infection, NleB1/NleB(CR) antagonizes death receptor-induced apoptosis of infected cells by modifying FADD in an irreversible manner. PMID: 28860194
- Using the tDED filament structure as a template, structural analyses reveal the interaction surfaces between FADD and caspase-8 and the distinct mechanisms of regulation by cFLIP and MC159 through comingling and capping, respectively. PMID: 27746017
- In myelodysplastic syndrome, FADD expression is regulated by SPAG6 which influences its interaction with TRAIL death receptors. PMID: 28393201
- High levels of FADD and caspase-8, but not caspase-3, were associated with increased incidence of coronary events in subjects from the general population. PMID: 28302628
- Both Fas associated via death domain gene copy number amplification and high protein expression were significantly associated with lymph node metastasis and had the shortest disease-free survival and overall survival. PMID: 27764170
- autoinflammation-associated H443P nlrc4 mutant is altered in interaction with SUG1 and ubiquitinated proteins, triggering constitutive caspase-8-mediated cell death dependent on FADD but independent of Ser(533) phosphorylation. PMID: 27974463
- this study shows that C5a signaling induces apoptosis in brain vascular endothelial cells in experimental lupus through activation of FADD PMID: 27213693
- Authors identify non-canonical nuclear factor-kappaB (NF-kappaB) signaling up regulated and it was directly linked with the tumor necrosis with MT2A and pFADD genes. pFADD with MT2A can inhibit the apoptosis and promote proliferation, of colorectal cancer cells. PMID: 28061540
- knockdown of cFLIPL and induced expression of FADD rapidly accumulate intracellular ROS accompanied by JNK1 activation to substantiate apoptosis. PMID: 27619661
- Data indicate that FADD mediated apoptotic cell death was directed by ubiquitination of cFLIPL and inhibition of NF-kappaB activation. PMID: 26972597
- Structural analysis for the roles of DR5 death domain mutations on oligomerization of DR5 death domain-FADD complex in the death-inducing signaling complex formation has been presented. PMID: 26995783
- A20 targets caspase-8 and FADD to protect HTLV-I-infected cells. PMID: 26437781
- TCGA analysis showed that ANO1 and FADD, located at 11q13, were co-expressed at transcript level and significantly associated with overall and disease-free survival PMID: 26808319
- Data (including data obtained in transgenic mice) suggest FADD is key in genesis of neural tube defects in pups of diabetic mice; unfolded protein response/endoplasmic reticulum stress was prevented by over-expression of human dominant negative FADD. PMID: 26419589
- multifaceted kinase, CK2, phosphorylates FADD and is involved in its sub-cellular localization. PMID: 26253696
- The gene expression analysis showed statistically significant difference between cases and healthy controls for both FADD (p<0.02) and FAS (p<0.007) genes PMID: 25129245
- Observed upregulation of cortical p-194 FADD and p-FADD/FADD ratio (higher pro-survival index) in major depression; could play a major role to counteract the known activation of the intrinsic (mitochondrial) apoptotic pathway in the brain PMID: 25075716
- FADD death effector domain and c-FLIP death effector domain structures, the binding activity of FADD DED to the c-FLIP death effector domains, and the protein-protein interactions involving the regulation of both apoptosis and necrosis. PMID: 24355299
- The genotype of the promoter SNP (rs10898853) of FADD was found to be significantly associated with papillary thyroid cancer in a South Korean case control study. PMID: 24434721
- These results indicate that FADD, as a host pro-apoptotic protein, plays important roles in regulating HIV-1 replication and production in several ways, and apoptotic pathway inhibition is able to decrease HIV-1 replication and production PMID: 24752353
- depletion of alphaNAC in multiple types of cancer cells induce typical apoptotic cell death. This anti-apoptotic function is mediated by the FADD/c-Jun N-terminal kinase pathway. PMID: 24901053
- high expression of FADD may be an independent biomarker for poor prognosis in nasopharyngeal carcinoma. PMID: 25305096
- Combined FADD, TMEM16A, and PPFIA1 gene expressions are associated with invasive ductal carcinoma of the breast. PMID: 24886289
- FADD elevation in leukocytes might be interpreted as the molecular equivalent of an elevated general inflammatory activity in relapsing remitting multiple sclerosis PMID: 24603611
- Antagonizing miR-128a expression sensitized Jurkat/R cells to the Fas-mediated apoptosis through derepression of FADD expression. PMID: 24316133
- association between FADD protein expression in advanced-stage head and neck squamous cell carcinoma and clinicopathological features and outcome PMID: 23763459
- Data show that calmodulin (CaM) binds to the death domain of Fas (FasDD) with an apparent dissociation constant (Kd) of ~2 muM and 2:1 CaM:FasDD stoichiometry. PMID: 23760276
- data show that Pin1 prevents Fas-mediated apoptosis in activated eosinophils via interactions with phospho-FADD PMID: 23606538
- Kashin-Beck disease patients have significant increased FADD expression in the middle layer but decreased FLIP expression in the upper layer of the cartilage. PMID: 22126763
- Ubiquitination and degradation of the FADD adaptor protein regulate death receptor-mediated apoptosis and necroptosis. PMID: 22864571
- The FADD gene amplification was not useful for the predictive marker of cancerization but is possibly related to the malignancy of oral squamous cell carcinoma. PMID: 22838074
- This review discusses the possible link that could exist between the adenosine-dependent regulation of FADD in the inflammatory context of rheumatoid arthritis. PMID: 22253026
- FADD cleavage by NK cell granzyme M enhances its self-association to facilitate procaspase-8 recruitment for auto-processing leading to caspase cascade. PMID: 21979465
- formation of hydrogen-bonded secondary structure in the C-terminal domain of the Fas-associated death domain PMID: 22130896
- DJ-1 protects against TRAIL-induced apoptosis through the regulation of death-inducing signaling complex (DISC) formation. PMID: 21785459
- Polo-like kinase 1 (Plk1) failed to phosphorylate the Aur-A-unphosphorylatable FADD substitution mutant S203A. PMID: 21978935
- an essential role of calmodulin in mediating Fas-induced FADD-independent activation of Src-ERK signaling pathways, which promote survival signaling in pancreatic cancer cells. PMID: 21613217
- FADD: an endogenous inhibitor of RIP3-driven regulated necrosis PMID: 21894190
- Our results suggest that deregulated miR-155 promotes Fas-mediated apoptosis in human intervertebral disc degeneration by targeting FADD and caspase-3 PMID: 21706480
- These data provide evidence that serine 194 phosphorylated Fas-associated death domain protein is involved in the proliferation of normal and neoplastic B cells and has features of a novel proliferation marker. PMID: 21315423
- FADD and TRIM21 together negatively regulate the late IFN-alpha pathway in response to viral infection. PMID: 21183682
- our data demonstrate that in response to taxol, Plk1 endows death-promoting and tumor-suppressor functions to its substrate, FADD PMID: 20890306
- Results suggest that the CD95-DD+CT:FADD-DD complex formed in solution is dissociated at the lower pH. PMID: 20947025
- findings show that the Fas-FADD death domain (DD) complex forms an asymmetric oligomeric structure composed of 5-7 Fas DD and 5 FADD DD, whose interfaces harbor associated autoimmune lymphoproliferative syndrome mutations PMID: 20935634
- FADD is essential at early stages of hematopoiesis; its deletion with the Mx1-cre transgene in bone marrow cells leads to impairment of peripheral lymphoid, myeloid, and erythroid cell lineages. PMID: 21115735
- describe here a complex clinical disorder, its genetic basis, and some of the key mechanisms underlying its pathogenesis. Our findings highlight the key role of FADD in Fas-dependent and Fas-independent signaling pathways in humans PMID: 21109225
顯示更多
收起更多
-
相關疾病:Infections, recurrent, associated with encephalopathy, hepatic dysfunction and cardiovascular malformations (IEHDCM)
-
組織特異性:Expressed in a wide variety of tissues, except for peripheral blood mononuclear leukocytes.
-
數據庫鏈接:
Most popular with customers
-
YWHAB Recombinant Monoclonal Antibody
Applications: ELISA, WB, IHC, IF, FC
Species Reactivity: Human, Mouse, Rat
-
Phospho-YAP1 (S127) Recombinant Monoclonal Antibody
Applications: ELISA, WB, IHC
Species Reactivity: Human
-
-
-
-
-
-